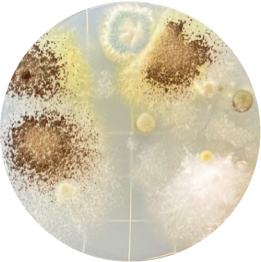
洗わなかったヘッド裏

-
「もったいない」
「しっかり掃除しなきゃ」
といった
気持ちを軽くする! -
ドライシートとウエットシートの両方を
準備したりつけ替える必要がなく、
手間と時間が削減! -
ドライシートとウエットシートを
手間なく一緒に使えて、
効率的に床がキレイに!
ドライ×ウエットシートを使った
“ちょこっと掃除”で
キレイを気楽に!
-

1部屋だけ掃除したい
洗面所だけ・トイレだけ・子どもがいない隙に
子ども部屋だけ、といった限られたスペースに -

汚れを見つけた!
たとえば廊下に泥だらけ靴下の足あとが…
放っておけないイヤな汚れに -

時間や気持ちに
余裕がない忙しくてしっかり掃除する余裕はないけど、
すぐキレイにしたい汚れに



- ※1 特定の菌(及びウイルス)・条件下で、ウエット面での効果を検証。すべての菌・ウイルスに同様の効果が得られるものではありません。
- ※2 エンベロープタイプのウイルス1種で、ウエット面での効果を検証。ウイルス除去は液が多い状態で行ってください。
シートをひっくり返すだけで
ドライとウエットを
使い分け
-

拭いたらシートをはずして
-

-


便利なだけじゃない
高い汚れ落とし性能
ドライ面・ウエット面ともに、
汚れをしっかり落とせる性能だから
ちょこっと掃除で気になる汚れをちゃんとキレイに!
ドライ面
太い繊維で、髪の毛などの汚れを
しっかり取り込む!



ウエット面
水分たっぷりのシートで
こびりついた汚れもきちんと落とす!




-
シートを両面使うと
汚れがちなヘッド裏も、


洗ったヘッド裏


洗わなかったヘッド裏

従来品キレキラ!ワイパー 徹底キレイ ウエットシートを使って床掃除し、シートを裏返してさらに掃除。
一方のヘッド裏は中性洗剤で水洗いし、もう一方は軽くゴミを取る程度の状態でそれぞれのヘッド裏に寒天培地を軽く押し当て菌を採取し、25℃で1週間培養した後の菌の発生数を比較。※当社基準、当社調べ。
-
角の汚れも、
中央のゴミも取りこぼしがちだけど、
































